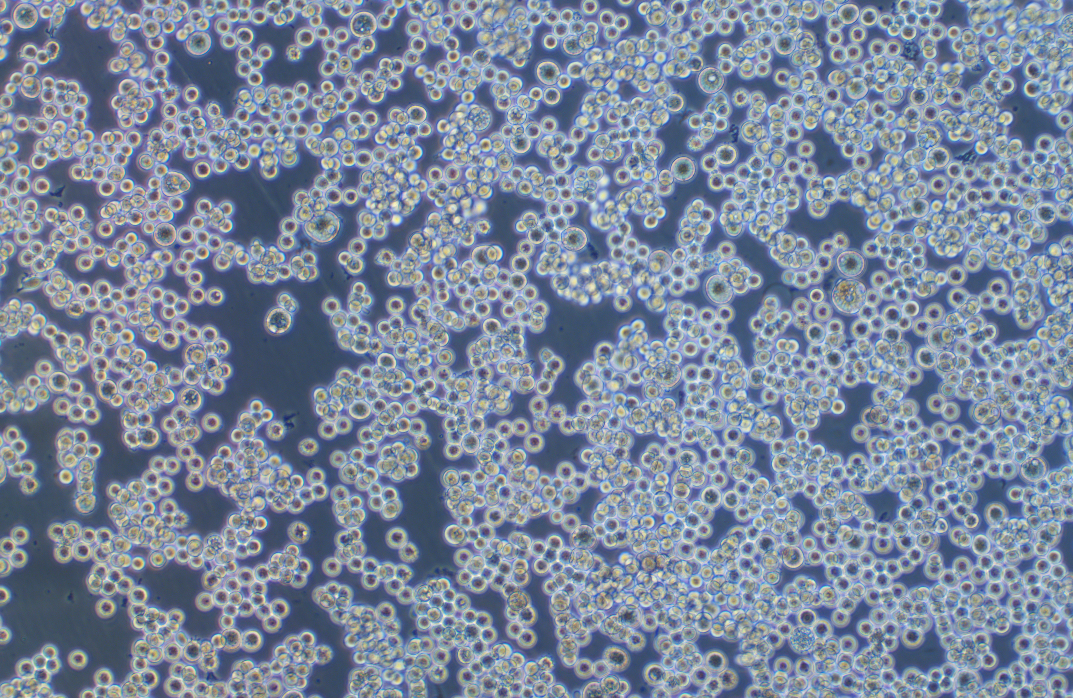

|
種屬 |
人 |
|
別稱 |
SK-Mel-1; SK Mel 1; SK-Mel 1; SK-Mel1; SKMEL-1; Sk MEL-1; SKMEL1; SK 1 |
|
組織來源 |
皮膚 |
|
疾病 |
惡性的黑色素瘤 |
|
傳代比例/細胞消化 |
1 :2-1:3傳代 ,維持細胞濃度在1×105~2×105cells/mL |
|
完全培養基配置 |
MEM培養基;10%胎牛血清;1%雙抗 |
|
簡介 |
該細胞由Oettgen F及其同事從一名29歲的患有廣泛、快速進展性惡性黑色素瘤的白人男性患者的胸導管中分離建立 的。該細胞可產生黑色素 ,電鏡檢測發現細胞中色素顆粒與自身合成和吞噬作用相關。在63%的惡性黑色素瘤患者和 10%其他疾病患者體內發現了針對該細胞系的抗體。 |
|
形態 |
球形的 |
|
生長特征 |
懸浮生長 |
|
倍增時間 |
~100h |
|
抗原表達 |
Blood Type A; Rh + |
|
致瘤性 |
Yes, in nude mice; forms pigmented malignant melanomas; also forms tumors in the cheek pouch of cortisone treated hamsters. |
|
STR |
Amelogenin :X ,Y ;CSF1PO :12 ,13 ;D13S317 :11 ;D16S539 :11 ,12 ;D18S51 :13 ,16 ; D19S433 :15 ,16.2 ;D21S11 :29 ,32.2 ;D2S1338 :19 ,23 ;D3S1358 :14 ,16 ;D5S818 :12 ,13 ; D7S820 :12 ;D8S1179 :16 ;FGA :18 ,20 ;TH01 :6 ;TPOX :11 ;vWA :16 ,17 ; |
|
培養條件 |
氣相 :空氣 ,95% ;二氧化碳 ,5%。 溫度 :37攝氏度 ,培養箱濕度為70%-80%。 |
|
凍存條件 |
凍存液 :90%FBS ,DMSO 10%, 或使用非程序凍存液 :官網貨號JY-H040 |
|
保藏機構 |
ATCC; HTB-67 |
|
備注 |
該細胞為懸浮細胞 ,請注意離心收集細胞懸液 ,請勿直接倒掉細胞培養液。 |
|
產品使用 |
僅限于科學研究 ,不可作為動物或人類疾病的治療產品使用。 |